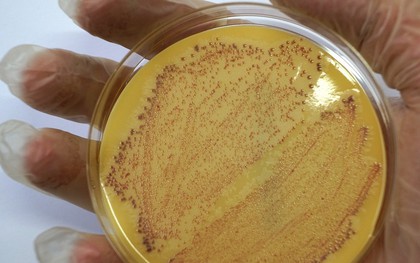

TIN TỨC VỀ đục lỗ phổi - duc lo phoi
đục lỗ phổi
-
Cô gái 29 tuổi vốn khỏe mạnh tử vong 10 ngày sau khi nhiễm siêu vi khuẩn "đục lỗ phổi"
Một người phụ nữ ở Úc đột ngột qua đời vài ngày sau khi nhiễm siêu vi khuẩn tấn công các cơ quan nội tạng và đục lỗ phổi.